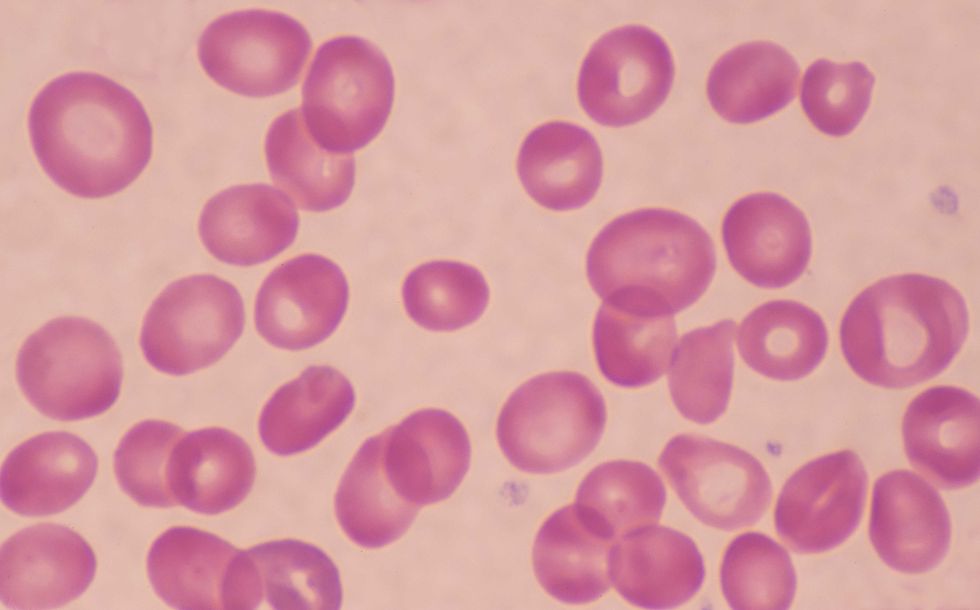
BLOOD CELLS UNDER MICROSCOPE

'I'm a dentist - the most telling signs of vitamin B12 deficiency often appear around the mouth'

WATCH NOW: New 'miracle supplement' can boost life expectancy, memory and eyesight
|GBN

Delaying the treatment of a vitamin B12 deficiency can leave you stuck with permanent complications
Don't Miss
Most Read
Latest
Vitamin B12 deficiency affects far more people than you might think, yet most of us know surprisingly little about this condition.
The real worry is that putting off treatment can leave you stuck with symptoms that won't go away, health experts are warning.
This is made worse by the fact that different countries can't seem to agree on what actually counts as a deficiency, making it harder for doctors to spot the condition.
But there's good news - a dentist from Manhattan has spotted four telltale signs that show up in your mouth during the early stages.
Getting a B12 deficiency diagnosed quickly really matters
|GETTY
Dr Sandip Sachar says some of the most distinct symptoms appear in the mouth, and they're worth knowing about.
She explained to GB News that the first one to watch for is angular cheilitis, characterised by painful cracks and sores that develop right at the corners of your mouth.
"Patients with B12 deficiency can develop painful fissures or cracks at the mouth corners. This is also called burning mouth syndrome," she said.
The reason this happens is that B12 helps keep your skin and the lining of your mouth healthy. Where these two types of tissue meet at the corners, it's already a vulnerable spot that moves a lot and tends to get dry.
When you don't have enough B12, these vulnerable areas simply can't heal properly. It's not just B12 deficiency that causes this - you'll see similar problems with some protein and other vitamin deficiencies too.
The second major sign Dr Sachar points to is mouth ulcers or sores that keep coming back.
"In the face of B12 deficiency, the immune system becomes less effective," she explained.
"This can lead to frequent or recurring infected oral ulcerations or sores that do not heal.".
It's a bit like angular cheilitis in that way - when your body lacks B12, your immune system struggles to do its job properly, which means those painful sores in your mouth just won't go away.
When to see a GP?
The NHS recommends booking an appointment if you suspect you might have a vitamin B12 or folate deficiency.
LATEST DEVELOPMENTS

Painful fissures around the mouth could be a sign of low B12 levels
|GETTY
The good news is that doctors can usually work out what's going on based on your symptoms and a simple blood test.
But prompt action is necessary, as the NHS stresses that getting diagnosed and treated quickly really matters.
While many symptoms do get better with treatment, some of the problems this deficiency causes can't be reversed.
That's why catching it early, especially when you spot those telltale mouth symptoms, could save you from lasting health issues.
Our Standards: The GB News Editorial Charter










